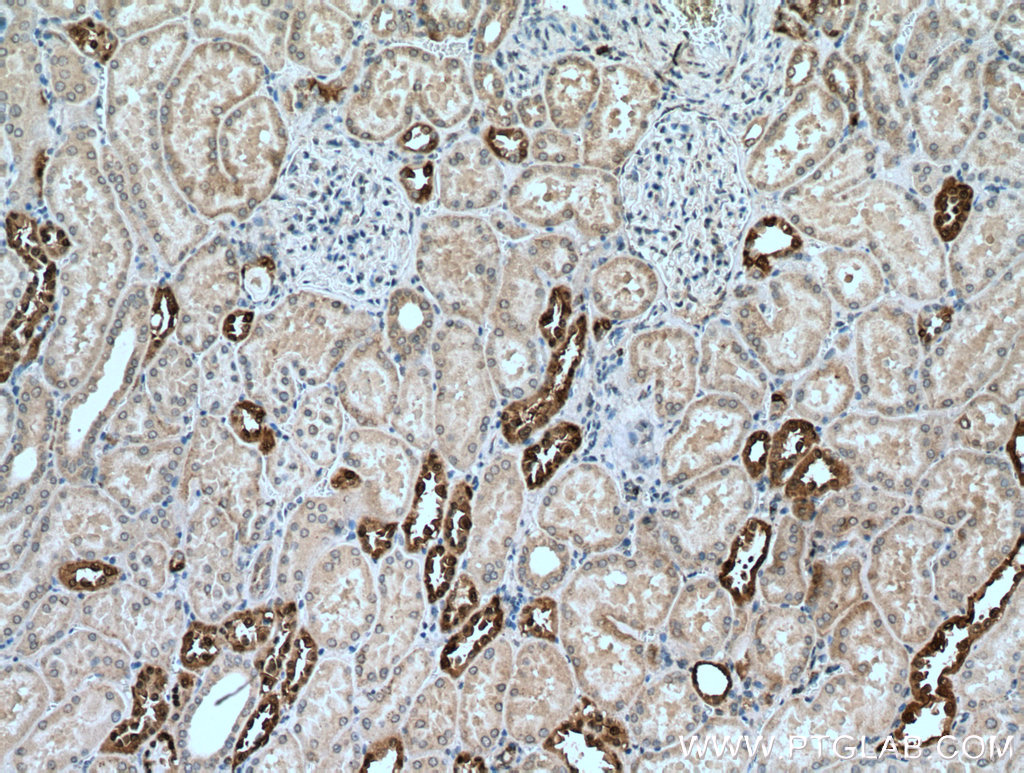

验证数据展示
经过测试的应用
| Positive WB detected in | HEK-293 cells, HepG2 cells |
| Positive IHC detected in | human kidney tissue Note: suggested antigen retrieval with TE buffer pH 9.0; (*) Alternatively, antigen retrieval may be performed with citrate buffer pH 6.0 |
推荐稀释比
| 应用 | 推荐稀释比 |
|---|---|
| Western Blot (WB) | WB : 1:2000-1:10000 |
| Immunohistochemistry (IHC) | IHC : 1:50-1:500 |
| It is recommended that this reagent should be titrated in each testing system to obtain optimal results. | |
| Sample-dependent, Check data in validation data gallery. | |
产品信息
26718-1-AP targets DUSP9 in WB, IHC, IF, ELISA applications and shows reactivity with human samples.
| 经测试应用 | WB, IHC, ELISA Application Description |
| 文献引用应用 | WB, IHC, IF |
| 经测试反应性 | human |
| 文献引用反应性 | human, mouse |
| 免疫原 |
CatNo: Ag25167 Product name: Recombinant human DUSP9 protein Source: e coli.-derived, PGEX-4T Tag: GST Domain: 343-384 aa of BC060837 Sequence: SLRLEERHSQEQGSGGQASAASNPPSFFTTPTSDGAFELAPT 种属同源性预测 |
| 宿主/亚型 | Rabbit / IgG |
| 抗体类别 | Polyclonal |
| 产品类型 | Antibody |
| 全称 | dual specificity phosphatase 9 |
| 别名 | dual specificity phosphatase 9, EC:3.1.3.16, MAP kinase phosphatase 4, Mitogen-activated protein kinase phosphatase 4, MKP 4 |
| 计算分子量 | 42 kDa |
| 观测分子量 | 42 kDa |
| GenBank蛋白编号 | BC060837 |
| 基因名称 | DUSP9 |
| Gene ID (NCBI) | 1852 |
| RRID | AB_2880612 |
| 偶联类型 | Unconjugated |
| 形式 | Liquid |
| 纯化方式 | Antigen affinity purification |
| UNIPROT ID | Q99956 |
| 储存缓冲液 | PBS with 0.02% sodium azide and 50% glycerol, pH 7.3. |
| 储存条件 | Store at -20°C. Stable for one year after shipment. Aliquoting is unnecessary for -20oC storage. |
背景介绍
Dual specificity protein phosphatase 9 (DUSP9) is also named itogen-activated protein kinase phosphatase 4 (MAP kinase phosphatase 4; MKP-4). DUSP9 is a typical DUSP characterized by the presence of an MKB/KIM motif and a phosphatase domain, which shares structural homology with other DUSPs (PMID: 25519881). DUSP9 is an important downstream regulator of BMP/Smad signaling and a key factor in maintaining the stemness of mESCs (PMID: 34768967). DUSP9 is one of the key genes involved in gonadotrophin-mediated ovarian follicle development (PMID: 33676987). DUSP9 expression increases during insulin-induced adipogenesis and culminates in mature adipocytes. DUSP9 as a key regulator of insulin signaling and highlighted its potential role in insulin resistance and metabolic diseases by dephosphorylating kinases involved in metabolic processes, glucose uptake and storage. DUSP9 can also impair the action of extracellular mediators and stress inducers (i.e., proinflammatory cytokines), which can induce insulin resistance by abnormally activating MAPK or SAP pathways (PMID: 30063256, PMID: 18296638). In normal mature tissues, DUSP9 is mainly expressed in kidney, adipose tissue and placenta, while it is only minimally present in brain, ovary, testis and urinary bladder (PMID: 34768967).
实验方案
| Product Specific Protocols | |
|---|---|
| IHC protocol for DUSP9 antibody 26718-1-AP | Download protocol |
| WB protocol for DUSP9 antibody 26718-1-AP | Download protocol |
| Standard Protocols | |
|---|---|
| Click here to view our Standard Protocols |
发表文章
| Species | Application | Title |
|---|---|---|
Front Immunol Identifying specific TLS-associated genes as potential biomarkers for predicting prognosis and evaluating the efficacy of immunotherapy in soft tissue sarcoma | ||
Sci Rep Inhibition of miR-194-5p avoids DUSP9 downregulation thus limiting sepsis-induced cardiomyopathy
| ||
Adv Sci (Weinh) Malignant Hepatoblast-Like Cells Sustain Stemness via IGF2-Dependent Cholesterol Accumulation in Hepatoblastoma |